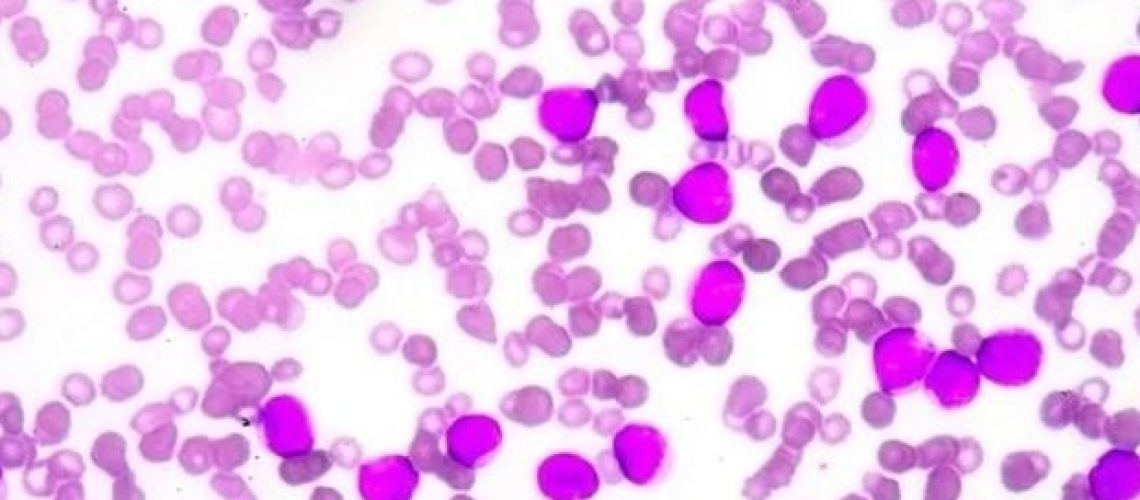
חולי אנמיה של Fanconi מראים הבדלים מטבוליים בולטים

מומחים מ-Cincinnati Children's חשפו הבדלים מטבוליים בולטים בקרב אנשים עם אנמיה של Fanconi (FA), הפרעה גנטית נדירה הגורמת לאי ספיקת מח עצם ומגבירה באופן דרמטי את הסיכון לסרטן.
הממצאים, שפורסמו ב-28 בנובמבר 2025, ב התקדמות המדעיכול לעצב מחדש את האופן שבו קלינאים חושבים על תזונה ומניעת סרטן פוטנציאלית באוכלוסייה פגיעה זו.
מה שהצוות גילה
בשיתוף פעולה עם התוכנית להשתלות מח עצם ומרכז הטיפול המקיף באנמיה ב-Fanconi ב-Cincinnati Children's, החוקרים השתמשו בטכניקה מתקדמת שנקראת "מטבולומיקה למעקב אחר איזוטופים". המשתתפים שתו כמות קטנה של גלוקוז עם אטומי פחמן "מתויגים" במיוחד, מה שמאפשר למדענים לעקוב בבטחה אחר האופן שבו הם נעים במסלולים המטבוליים של הגוף ועובדו בזמן אמת. גישה זו סיפקה הערכה דינמית ראשונה מסוגה של חילוף החומרים התזונתיים באוכלוסייה זו.
התוצאות היו בלתי צפויות. במקום להשתמש ביעילות בגלוקוז, אנשים עם FA הראו:
- סוכר בדם שנשאר גבוה וירידה בכמות האנרגיה שגופם שרף לאחר נטילת משקה גלוקוז.
- מעבר לשריפת שומן לדלק, עם רמות גבוהות יותר של קטונים – למרות שלגופם היה הרבה גלוקוז זמין.
- סימנים לכך שגופם לא הגיב טוב לאינסולין, כולל רמות גבוהות מהרגיל של חומצות אמינו מסוימות.
"הדפוסים הללו חושפים חוסר גמישות מטבולית עמוקה", אומרת המחברת הראשונה והמשתתפת של המחקר, שרה ויסנטה-מוניוז, דוקטורט, מדענית במתקן המטבולומי התרגום בחטיבה לפתולוגיה ורפואת מעבדה ב-Cincinnati Children's. "נראה שאנשים עם FA עוקפים את חמצון הגלוקוז הרגיל, מה שעשוי להשפיע גם על הבריאות הכללית וגם על הסיכון לסרטן."
למה זה חשוב
אנמיה של Fanconi משפיעה על כמעט כל מערכת איברים ומגדירה חולים לסרטן אגרסיבי. הבנה כיצד FA חווט מחדש את חילוף החומרים באנרגיה יכולה להוביל לאסטרטגיות חדשות לשיפור הבריאות והפחתת הסרטן.
מחקר זה גם מראה כיצד מטבולומיקה של מעקב אחר איזוטופים יכולה לקדם מחקר תרגום. אותה גישה יכולה לעזור לחוקרים לחשוף בעיות מטבוליות במצבים רבים, כולל סוכרת, סרטן והפרעות גנטיות נדירות אחרות.
עבודה זו משקפת שנים של מאמץ ומדגישה את הכוח של מטבולומיקה מתקדמת להאיר את מנגנוני המחלה. הצעד הבא שלנו הוא מחקר היתכנות בילדים עם FA כדי לבדוק אם דיאטה דלת פחמימות יכולה לשפר את הבריאות המטבולית".
לינדזי רומיק, דוקטורט, סופרת מקבילה ומנהלת המתקן למטבולומי מתרגלי
Cincinnati Children's היא בין קומץ מוסדות עם מומחים כמו Vicente-Muñoz עם מומחיות עמוקה במטבולומיה יציבה של איזוטופים.
"מערך הכישורים הנדיר שלה מאפשר לה לא רק לעבד ולנתח מערכי נתונים איזוטופים מורכבים במיוחד, אלא גם לפרש את הדפוסים המתקבלים בדרכים שחושפות סיפורים ביולוגיים משמעותיים", אומר רומיק.
בעוד שתוצאות אלו מהוות צעד מרגש קדימה עבור אנשים עם FA, רומיק ושותפי הפעולה שלה מהמכון למחלות סרטן ומחלות דם מזהירים מאוד את המשפחות לגבי ביצוע שינויים תזונתיים בעצמם. "אנשים עם FA שבריריים מבחינה רפואית וזקוקים להמשך הדרכה של מומחים", מציין רומיק. "משפחות צריכות להתייעץ עם הספק של ילדן".
לגבי המחקר
מחברים שותפים מ-Cincinnati Children's כללו את סטלה דייויס, MBBS, PhD, MRCP (השתלת מח עצם ומחסור חיסוני), Thomas Galletta, MD (אונקולוגיה), Khyati Mehta, PhD (Sclinical Mass Spectrometry and Biomedical Informatics), וסוזאן סאמר, MS, CRD (Schubert Research). אנדרו ליין, דוקטורט, מאוניברסיטת קנטקי תרם אף הוא למחקר.
עבודת המחקר עבור מחקר זה נתמכה על ידי מתקני הליבה הללו ב-Cincinnati Children's: מתקן הציטומטריה של זרימת המחקר, המתקן לחקר ביו-תזונה ומתקן המטבולומי התרגום.
מקורות המימון כוללים את קרן Fanconi Cancer ואת תכנית המדע הקליני והתרגום (CTSA), מענק UL1TR001425. תוכנית ה-CTSA מנוהלת על ידי המרכז הלאומי לקידום מדעי התרגום (NCATS) של ה-NIH.